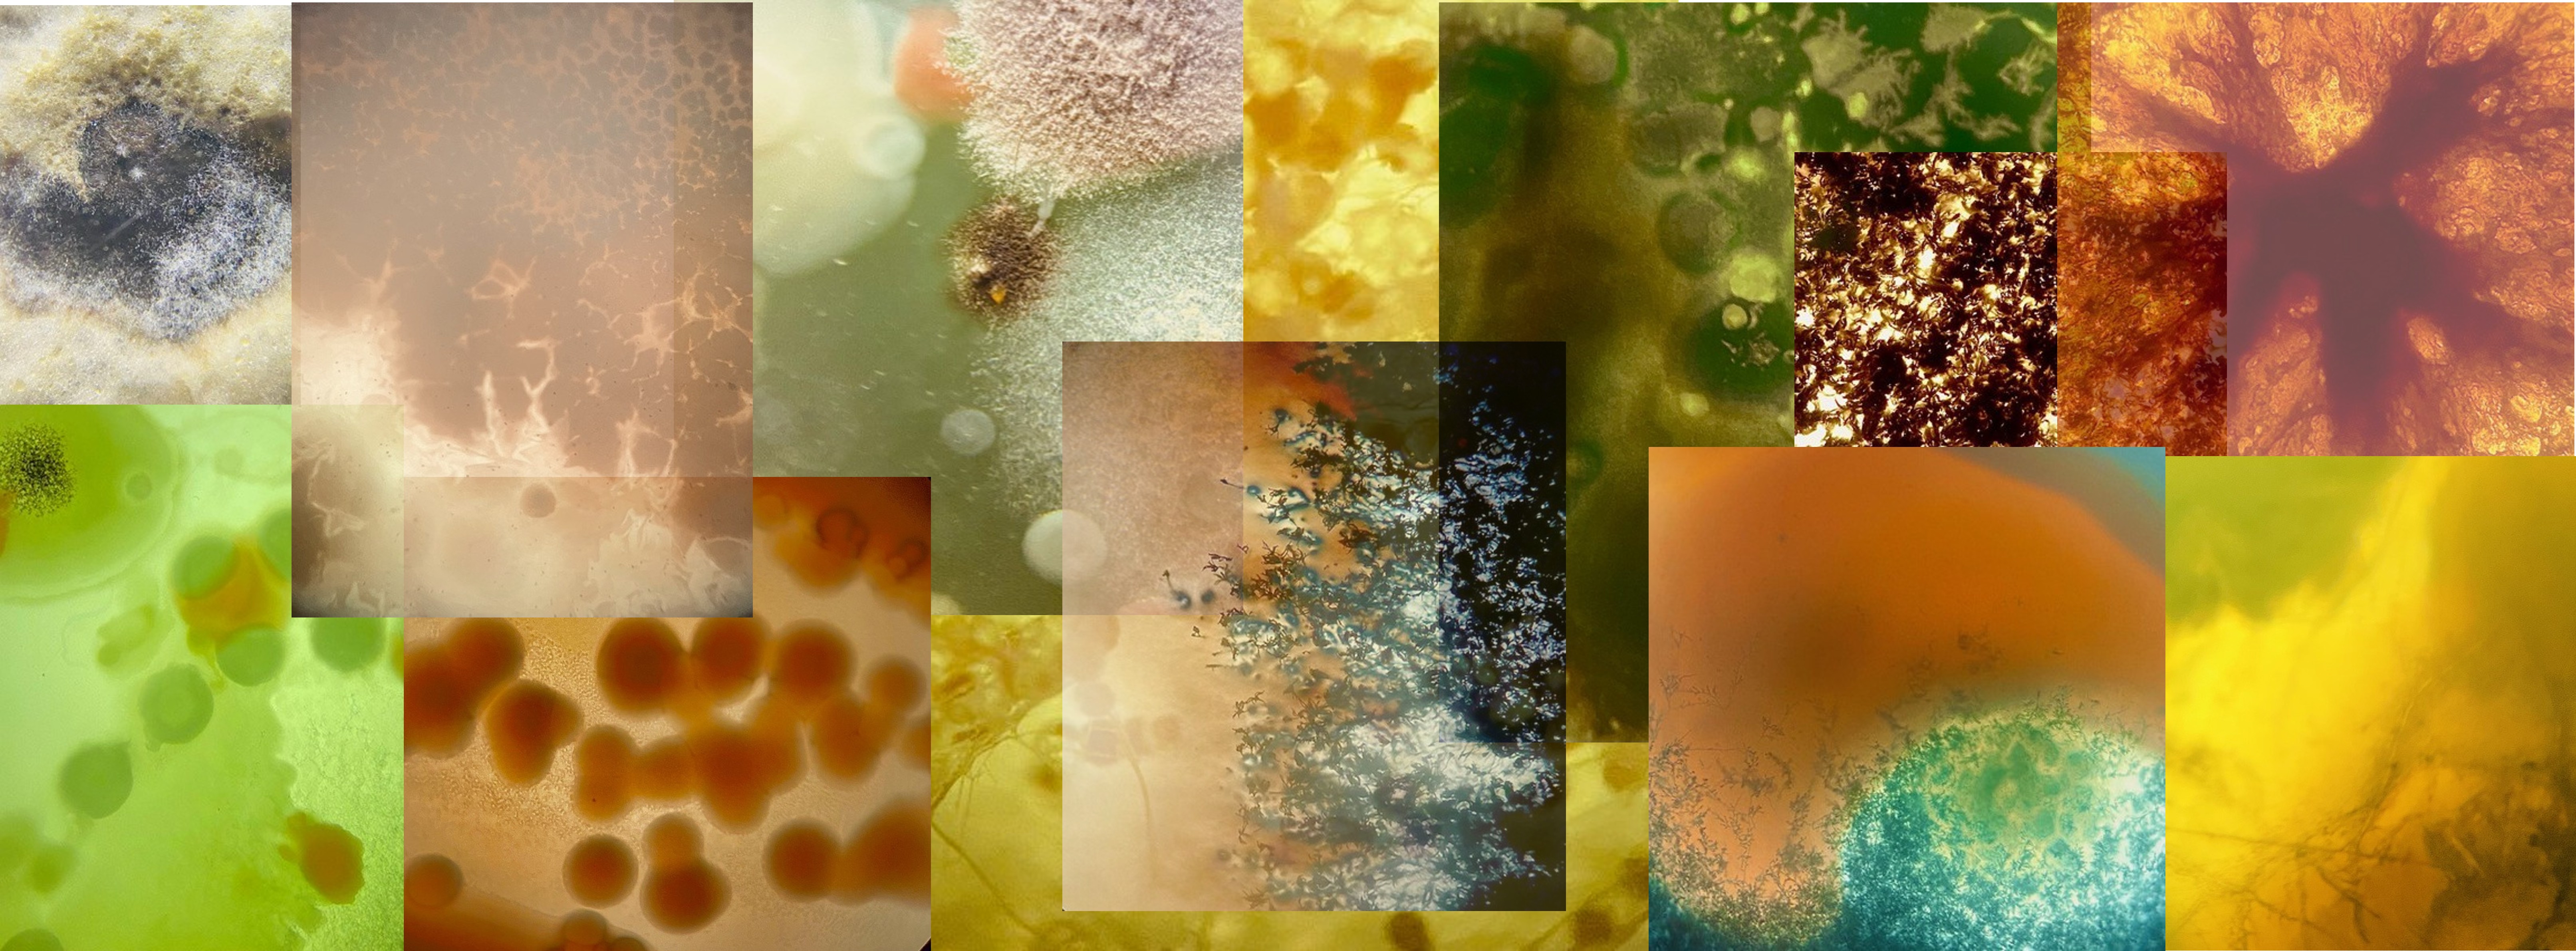
Microbial biopigments visualization

Week 1 HW: Principles and Practices
Introduction
During the HTGAA program, I am interested in developing a biological engineering application focused on the production of microbial biopigments using sustainable and bio-based approaches. Based on my previous experience working with biocolorants and the revalorization of agro-industrial waste, I am particularly motivated to explore microbial pigments as functional biomolecules with applications beyond coloration. Microbial pigments are known for their vibrant hues and, unlike many synthetic pigments, they often exhibit nutritional, antioxidant, and therapeutic properties. These pigments are already used in pharmaceutical, food, textile, and paint industries, and some bacterial pigments are currently being investigated as alternative medical agents for cancer treatment and antibacterial applications. Through this project, I aim to study the production, optimization, and potential functional applications of microbial pigments, while exploring their future use as sustainable and value-added alternatives in the food and pharmaceutical industries.
To ensure that the development of microbial biopigments contributes to an ethical, safe, and socially beneficial future, several governance and policy goals should be considered. These goals focus on non-malfeasance, environmental responsibility, equity, and responsible innovation.
Ensure Safety and Non-Malfeasance
A primary goal is to prevent harm to human health, ecosystems, and laboratory workers during the production and application of microbial pigments.
- Biosafety in production: Ensure that only non-pathogenic, well-characterized microorganisms are used, following appropriate biosafety level (BSL-1) practices and containment protocols.
- Product safety assessment: Establish standardized testing to evaluate toxicity, allergenicity, and stability of biopigments before their use in food, pharmaceutical, or cosmetic applications.
- Waste and byproduct management: Implement protocols for the safe treatment and disposal of biological waste to prevent environmental contamination.
Promote Environmental Sustainability
Because this application aims to replace synthetic pigments, governance should reinforce genuine environmental benefits rather than greenwashing.
- Life-cycle assessment (LCA): Encourage evaluation of the full environmental footprint, including raw materials, energy use, water consumption, and waste generation.
- Circular bioeconomy integration: Prioritize the use of agro-industrial residues as feedstocks, reducing waste while creating added value.
- Scalable but responsible production: Avoid practices that lead to excessive resource extraction or unintended ecological impacts at industrial scale.
Prevent Misuse and Ensure Responsible Innovation
Although microbial pigments are generally low-risk, governance should anticipate dual-use concerns and inappropriate applications.
- Clear application boundaries: Define acceptable uses (e.g., food, textiles, pharmaceuticals) and discourage applications that could mislead consumers or pose hidden risks.
- Transparency in research and labeling: Require clear documentation of microbial sources, production methods, and functional claims to avoid misinformation.
- Ethical research oversight: Promote review processes that evaluate both technical feasibility and societal implications during development.
Advance Equity and Accessibility
An ethical future also requires that the benefits of biotechnological innovation are shared broadly, especially with communities involved in resource generation.
- Fair use of agro-industrial waste: Ensure that sourcing of residues does not exploit small producers or displace local uses.
- Knowledge sharing and capacity building: Promote open science, technology transfer, and training opportunities, particularly in regions where agricultural waste is abundant.
- Affordable end products: Encourage policies that prevent excessive cost barriers so sustainable pigments are accessible to small industries and local markets.
Support Regulatory Alignment and Public Trust
Strong governance should align innovation with existing regulations while fostering public confidence.
- Regulatory compliance: Ensure alignment with food, pharmaceutical, and environmental regulations at national and international levels.
- Public engagement: Communicate clearly about the benefits and limitations of microbial pigments to build trust and acceptance.
- Evidence-based claims: Require scientific validation for nutritional or therapeutic claims to avoid overpromising or misleading consumers.
| Option | Safety & Biosecurity | Sustainability | Transparency | Equity |
|---|---|---|---|---|
| Biosafety: | 1 | 2 | 2 | n/a |
| Sustainability Incentives | 2 | 1 | 2 | 3 |
| Ethical Oversight & Engagement | 2 | 2 | 1 | 1 |
| 1 = Best alignment |
Conclusion
Together, these governance actions balance scientific freedom with responsibility, ensuring that microbial biopigments contribute positively to health, sustainability, and social trust. Rather than restricting innovation, they create a framework where ethical, safe, and environmentally conscious biotechnology can thrive.